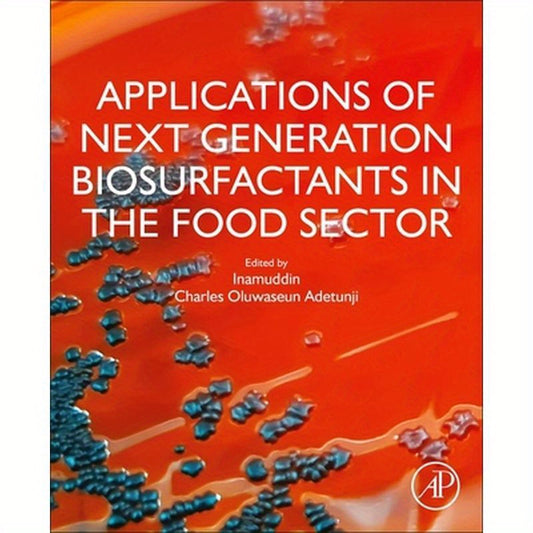
Applications of Next Generation Biosurfactants in the Food Sector

Collection: Products
-
Applications of Next Generation Biosurfactants in the Food Sector
Regular price $230.00Regular price -
Applications of Nonlinear Fiber Optics
Regular price $155.00Regular price -
Applications of Nuclear and Radioisotope Technology: For Peace and Sustainable Development
Regular price $185.00Regular price -
Applications of Polymers and Plastics in Medical Devices: Design, Manufacture, and Performance
Regular price $235.00Regular price -
Applications of Polymers in Drug Delivery
Regular price $255.00Regular price -
Applications of Polyurethanes in Medical Devices
Regular price $235.00Regular price -
Applications of Quantum and Classical Connections in Modeling Atomic, Molecular and Electrodynamic Systems
Regular price $54.95Regular price -
Applications of Random Process Excursion Analysis
Regular price $155.00Regular price -
Applications of Semi-Analytical Methods for Nanofluid Flow and Heat Transfer
Regular price $225.00Regular price -
Applications of Targeted Nano Drugs and Delivery Systems: Nanoscience and Nanotechnology in Drug Delivery
Regular price $225.00Regular price -
Applications of Viscoelasticity: Bituminous Materials Characterization and Modeling
Regular price $205.00Regular price -
Applications to Wind Up Companies
Regular price $415.00Regular price -
Applicative Constructions
Regular price $245.00Regular price -
Applied Analysis of Composite Media: Analytical and Computational Results for Materials Scientists and Engineers
Regular price $230.00Regular price -
Applied Behavior Analysis
Regular price $178.32Regular price -
Applied Biomechatronics Using Mathematical Models
Regular price $155.00Regular price -
Applied Biomedical Engineering Using Artificial Intelligence and Cognitive Models
Regular price $205.00Regular price -
Applied Clinical Pharmacokinetics 3/E
Regular price $96.00Regular price -
Applied Computing in Medicine and Health
Regular price $135.00Regular price -
Applied Creep Mechanics
Regular price $208.00Regular price -
Applied Demography for Biologists: With Special Emphasis on Insects
Regular price $385.00Regular price -
Applied Demography: Applications to Business, Government, Law and Public Policy
Regular price $180.99Regular price -
Applied Dimensional Analysis and Modeling
Regular price $175.00Regular price -
Applied Drought Modeling, Prediction, and Mitigation
Regular price $135.00Regular price